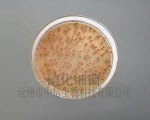
供应硝化细菌

产品列表
-
¥面议/吨广东S 深圳市
-
¥面议/吨内蒙古C 赤峰市
-
三.作用与用途: 本品以糖蜜、淀粉、玉米蛋白粉、小麦麸、各种饼粕、复合氨基酸等为主要原料,经液体培养,固体接种发酵,干燥后制得的含活酵母细胞和培养物的产品,并具有蛋白酶、淀粉酶等多种消化酶、维生素、微量......¥面议/吨河北 沧州市
-
¥面议/吨北京F 房山区
-
1、能迅速分解水产动物的排泄物,残铒及有机污物,消除水体臭味,净化水质,提高透明度。 2、能有效降解亚硝酸盐、氨、氮及硫化氢等有毒物质,优化养殖环境。 ......¥面议/吨河北 沧州市
-
¥面议/吨河北 沧州市
-
¥面议/吨山东L 临沂市
-
1、降低水产养殖水体中所产生的氨氮和亚硝酸盐含量,改善水体,减少或降低氨氮及亚硝酸盐对水产养殖动物的危害,确保养殖生产安全。 2、分解水体中及塘底的有机物质,从根本上切断亚硝酸盐、氨、氮的主要来 源,维持水体生......¥面议/吨河北 沧州市
-
¥面议/吨河北 沧州市
-
¥面议/吨北京 昌平区
-
¥面议/吨北京 昌平区
-
HD9200A兽用掌上全数字B型超声诊断仪 - 扫描方式:机械扇扫 - 扫描深度:192mm - 监视器尺寸:5.6英寸TFT-LCD - 显示模式:B、B+B、B+M、M - 图像灰阶:256级......¥面议/台辽宁D 丹东市